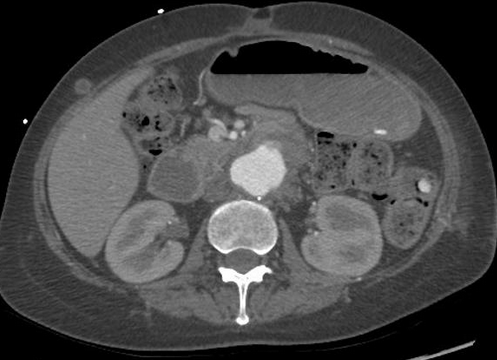
Abdominal CT scan. Distended small bowel loops with fluid content (Courtesy Dr. V. Penopoulos)
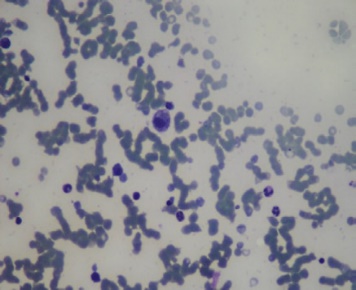
A  metastatic  deposit  on  the  excised  gallbladder (Courtesy Dr. V. Penopoulos)

Upper Abdomen
Άνω Κοιλία
224 images · 3 sub-chapters

Gastroscopy. Green arrows: orifice of the gastrocolic fistula (Courtesy Dr. V. Penopoulos)

Repeat abdominal CT scan demonstrating complete resorption and disappearance of air from the stomach and the portal venous system (Courtesy Dr. V. Penopoulos)

Repeat abdominal CT scan demonstrating complete resorption and disappearance of air from the stomach and the portal venous system (Courtesy Dr. V. Penopoulos)

Electron micrograph demonstrating the SIP syncytium in the guinea pig stomach. Panel A, Mitsui & Komuro. Cell Tissue Res 2002;309:219-227; Panel B-D, Sung TS, et al. J Physiol 2018;596:1549-1574; Panel E, Sanders KM et al. J Physiol 2010;588:4621-4639 (Courtesy Dr. V. Penopoulos)

Gastrointestinal motility disorders in neurological diseases. J Clin Invest 2021;131:e143771 (Courtesy Dr. V. Penopoulos)

Electron micrograph demonstrating the SIP syncytium in the guinea pig stomach. Panel A, Mitsui & Komuro. Cell Tissue Res 2002;309:219-227; Panel B-D, Sung TS, et al. J Physiol 2018;596:1549-1574; Panel E, Sanders KM et al. J Physiol 2010;588:4621-4639 (Courtesy Dr. V. Penopoulos)

Electron micrograph demonstrating the SIP syncytium in the guinea pig stomach. Panel A, Mitsui & Komuro. Cell Tissue Res 2002;309:219-227; Panel B-D, Sung TS, et al. J Physiol 2018;596:1549-1574; Panel E, Sanders KM et al. J Physiol 2010;588:4621-4639 (Courtesy Dr. V. Penopoulos)

Electron micrograph demonstrating the SIP syncytium in the guinea pig stomach. Panel A, Mitsui & Komuro. Cell Tissue Res 2002;309:219-227; Panel B-D, Sung TS, et al. J Physiol 2018;596:1549-1574; Panel E, Sanders KM et al. J Physiol 2010;588:4621-4639 (Courtesy Dr. V. Penopoulos)

Electron micrograph demonstrating the SIP syncytium in the guinea pig stomach. Panel A, Mitsui & Komuro. Cell Tissue Res 2002;309:219-227; Panel B-D, Sung TS, et al. J Physiol 2018;596:1549-1574; Panel E, Sanders KM et al. J Physiol 2010;588:4621-4639 (Courtesy Dr. V. Penopoulos)

Abdominal computed tomography. Atonic, distended stomach, filled with food residue (Courtesy Dr. V. Penopoulos)

Postoperative barium esophagography. Smooth passage of contrast through the myotomy site (Courtesy Dr. V. Penopoulos)

Hiatal hernia cavity and complete closure/repair without mesh (Courtesy Dr. V. Penopoulos)

Immunohistochemical staining with anti-CD117 antibody – Positive expression in mast cells and negative expression in elongated spindle cells (Courtesy Dr. V. Penopoulos)

Immunohistochemical staining with anti-CD117 antibody – Positive expression in mast cells and negative expression in elongated spindle cells (Courtesy Dr. V. Penopoulos)

Immunohistochemical staining with anti-CD117 antibody – Positive expression in mast cells and negative expression in elongated spindle cells (Courtesy Dr. V. Penopoulos)

Immunohistochemical staining with anti-CD117 antibody – Positive expression in mast cells and negative expression in elongated spindle cells (Courtesy Dr. V. Penopoulos)

Infiltration of the submucosal layer with granulation tissue (Courtesy Dr. V. Penopoulos)

Preservation of the mucosa is evident, with mildly hypertrophic appearance of the muscularis mucosae (Courtesy Dr. V. Penopoulos)

Inflammatory fibroid polyp of the duodenum – Complete endoscopic removal of the IFP (Courtesy Dr. V. Penopoulos)

Abdominal CT scan. Red outline – Inflammatory fibroid polyp of the duodenum (Courtesy Dr. V. Penopoulos)

Yellow arrow — Thick-walled gallbladder with gallstones. Blue arrow — Stomach segment. Light blue arrows — Cholecystogastric fistula (Courtesy Dr. V. Penopoulos)

Yellow arrow — Thick-walled gallbladder with gallstones. Blue arrow — Stomach segment. Light blue arrows — Cholecystogastric fistula (Courtesy Dr. V. Penopoulos)

Yellow arrow — Thick-walled gallbladder with gallstones. Blue arrow — Stomach segment. Light blue arrows — Cholecystogastric fistula (Courtesy Dr. V. Penopoulos)

Plain abdominal radiographs. Small bowel loop distension. Red arrow — Radiopaque mass (gallstone) (Courtesy Dr. V. Penopoulos)

Yellow arrow — Thick-walled gallbladder with gallstones. Blue arrow — Stomach segment. Light blue arrows — Cholecystogastric fistula (Courtesy Dr. V. Penopoulos)

Yellow arrow — Thick-walled gallbladder with gallstones. Blue arrow — Stomach segment. Light blue arrows — Cholecystogastric fistula (Courtesy Dr. V. Penopoulos)

Yellow arrow — Thick-walled gallbladder with gallstones. Blue arrow — Stomach segment. Light blue arrows — Cholecystogastric fistula (Courtesy Dr. V. Penopoulos)

Yellow arrow — Thick-walled gallbladder with gallstones. Blue arrow — Stomach segment. Light blue arrows — Cholecystogastric fistula (Courtesy Dr. V. Penopoulos)

Yellow arrow — Thick-walled gallbladder with gallstones. Blue arrow — Stomach segment. Light blue arrows — Cholecystogastric fistula (Courtesy Dr. V. Penopoulos)

Yellow arrow — Thick-walled gallbladder with gallstones. Blue arrow — Stomach segment. Light blue arrows — Cholecystogastric fistula (Courtesy Dr. V. Penopoulos)

Detail of the lesser curvature of the stomach. Early ischemic changes (Courtesy Dr. V. Penopoulos)

Extreme stenosis of the involved transverse colon . Residual seeds were unable to overcome the stenotic segment (Courtesy Dr. V. Penopoulos)

Postoperative stricture development at the esophagogastric anastomosis (Courtesy Dr. V. Penopoulos)

Acid ingestion (HCL). Diffuse burns and contraction/shrinkage of both the esophagus and stomach (Courtesy Dr. V. Penopoulos)

Performance of transthoracic esophagojejunal anastomosis (Courtesy Dr. V. Penopoulos)

Gastrografin swallow - Colonojejunal anastomosis following esophagogastrectomy for extensive esophageal and gastric burns (Courtesy Dr. V. Penopoulos)

Gastrografin swallow - Esophagogastric anastomosis (stomach within the right hemithorax) (Courtesy Dr. V. Penopoulos)

Esophagectomy - The endoprosthesis (stent) within the organ lumen is visible (Courtesy Dr. V. Penopoulos)

Postoperative stricture development at the esophagogastric anastomosis (Courtesy Dr. V. Penopoulos)

Postoperative stricture development at the esophagogastric anastomosis (Courtesy Dr. V. Penopoulos)

Postoperative stricture development at the esophagogastric anastomosis (Courtesy Dr. V. Penopoulos)

Postoperative stricture development at the esophagogastric anastomosis (Courtesy Dr. V. Penopoulos)

Postoperative stricture development at the esophagogastric anastomosis (Courtesy Dr. V. Penopoulos)

Postoperative stricture development at the esophagogastric anastomosis (Courtesy Dr. V. Penopoulos)

Postoperative stricture development at the esophagogastric anastomosis (Courtesy Dr. V. Penopoulos)

Postoperative stricture development at the esophagogastric anastomosis (Courtesy Dr. V. Penopoulos)

Postoperative stricture development at the esophagogastric anastomosis (Courtesy Dr. V. Penopoulos)

Postoperative stricture development at the esophagogastric anastomosis (Courtesy Dr. V. Penopoulos)

Postoperative stricture development at the esophagogastric anastomosis (Courtesy Dr. V. Penopoulos)

Postoperative stricture development at the esophagogastric anastomosis (Courtesy Dr. V. Penopoulos)

Postoperative stricture development at the esophagogastric anastomosis (Courtesy Dr. V. Penopoulos)

Postoperative stricture development at the esophagogastric anastomosis (Courtesy Dr. V. Penopoulos)

Postoperative stricture development at the esophagogastric anastomosis (Courtesy Dr. V. Penopoulos)

Different views of a double contrast-enhanced CT scan showing a left diaphragmatic hernia with an acute dilated stomach (Courtesy Dr. V. Penopoulos)

Diaphragmatic hernia before and after reduction of the stomach (Courtesy Dr. V. Penopoulos)

Water-soluble gastrografin meal showing postoperative normal positioning of stomach (Courtesy Dr. V. Penopoulos)

Water-soluble gastrografin meal showing postoperative normal positioning of stomach (Courtesy Dr. V. Penopoulos)

Water-soluble gastrografin meal showing postoperative normal positioning of stomach (Courtesy Dr. V. Penopoulos)

Duodenectomy sparing Vater s papilla .Poorly differentiated adenocarcinoma invading full thickness the duodenal wall and surrounding fatty tissue with clear cut margins (Courtesy Dr. V. Penopoulos)

Neuroendocrine carcinoma (NEC) consisting of poorly differentiated tumor cells with many mitosis forming solid sheets and nests

Gastrectomy specimen. Green arrow - Mucus Adenocarcinoma. Blue arrow - Neuroendocrine Carcinoma

CT Scan. The gastric tumors are obvious (red arrow). Incidental finding right sided sizable renal cysts (blue arrow)

The jejunal interposition loop is clearly seen ( Merendino’s technique ) (Courtesy Dr. V. Penopoulos)

The jejunal interposition loop is clearly seen ( Merendino’s technique ) (Courtesy Dr. V. Penopoulos)

The jejunal interposition loop is clearly seen ( Merendino’s technique ) (Courtesy Dr. V. Penopoulos)

The jejunal interposition loop is clearly seen ( Merendino’s technique ) (Courtesy Dr. V. Penopoulos)

The jejunal interposition loop is clearly seen ( Merendino’s technique ) (Courtesy Dr. V. Penopoulos)

The jejunal interposition loop is clearly seen ( Merendino’s technique ) (Courtesy Dr. V. Penopoulos)

Contrast-enhanced CT of the abdomen, revealed a grossly distended stomach with mild diffuse thickening of its wall (red arrow)

Recordings of the left recurrent laryngeal nerve potentials, before and after removal of the left thyroid lobe (Courtesy Dr. V. Penopoulos)

White arrows indicate the leak from the posterior esophageal wall (Courtesy Dr. V. Penopoulos)

Adenosquamous carcinoma of the upper third of the esophagus (Courtesy Dr. V. Penopoulos)

Contrast-enhanced CT of the abdomen, revealing air in intrahepatic biliary tree (pneumobilia) (red arrow)

Complete mobilization of the upper esophagus and encirclement with Penrose drains (Courtesy Dr. V. Penopoulos)

Upper gastrointestinal endoscopy showing a grossly deformed duodenal bulb. A steady trickle of bile was also seen to come from a slit-like orifice on the anterior duodenal wall suggestive of biliary duodenal fistula (green arrow)

Esophagography. Arrows demonstrate a small posterior pseudodiverticulum of the esophagus adjacent to the metallic plate and screws (Courtesy Dr. V. Penopoulos)

Esophagography. Arrows demonstrate a small posterior pseudodiverticulum of the esophagus adjacent to the metallic plate and screws (Courtesy Dr. V. Penopoulos)

Esophagoscopy. Green arrow: Esophageal pseudodiverticulum (Courtesy Dr. V. Penopoulos)

Green arrow: Sternocleidomastoid muscle. Blue arrow: Esophagus (Courtesy Dr. V. Penopoulos)

Esophagojejunal anastomosis - endoscopic image on the 30th postoperative day (Courtesy Dr. V. Penopoulos).

Normal jejunojejunal anastomosis (lower Roux anastomosis) (Courtesy Dr. V. Penopoulos).

Green arrows — reconstruction of the Nissen fundoplication (Courtesy Dr. V. Penopoulos)

Postoperative image of long myotomy. Green outline — the divided muscular layers of the esophagus. The esophageal mucosa is exposed at the center. The myotomy extends onto the stomach (Courtesy Dr. V. Penopoulos)

Barium swallow. Red arrow — previous Nissen fundoplication. Yellow arrow — narrowed distal esophagus with tapering of its terminal segment. Green outline — right paraesophageal hiatal hernia (Courtesy Dr. V. Penopoulos)
Abdominal CT scan. Distended small bowel loops with fluid content (Courtesy Dr. V. Penopoulos)

Anatomical forceps within the fistula orifice in the duodenum (Courtesy Dr. V. Penopoulos)

Anatomical forceps within the fistula orifice in the duodenum (Courtesy Dr. V. Penopoulos)

Total gastrectomy specimen. Brown arrows – Multiple gastric stromal tumors (Courtesy Dr. V. Penopoulos)

Total gastrectomy specimen. Brown arrows – Multiple gastric stromal tumors (Courtesy Dr. V. Penopoulos)

Total gastrectomy specimen. Brown arrows – Multiple gastric stromal tumors (Courtesy Dr. V. Penopoulos)

Total gastrectomy specimen. Brown arrows – Multiple gastric stromal tumors (Courtesy Dr. V. Penopoulos)

Total gastrectomy specimen. Brown arrows – Multiple gastric stromal tumors (Courtesy Dr. V. Penopoulos)

Total gastrectomy specimen. Brown arrows – Multiple gastric stromal tumors (Courtesy Dr. V. Penopoulos)

Total gastrectomy specimen. Brown arrows – Multiple gastric stromal tumors (Courtesy Dr. V. Penopoulos)

Red arrows – Rectal stromal tumor. Multiple liver metastases (Courtesy Dr. V. Penopoulos)

Total gastrectomy specimen. Brown arrows – Multiple gastric stromal tumors (Courtesy Dr. V. Penopoulos)

Endoscopic view of multiple gastric stromal tumors after suctioning of hemorrhagic products (Courtesy Dr. V. Penopoulos)

Total gastrectomy specimen. Brown arrows – Multiple gastric stromal tumors (Courtesy Dr. V. Penopoulos)

Total gastrectomy specimen. Brown arrows – Multiple gastric stromal tumors (Courtesy Dr. V. Penopoulos)

Total gastrectomy specimen. Brown arrows – Multiple gastric stromal tumors (Courtesy Dr. V. Penopoulos)

Total gastrectomy specimen. Brown arrows – Multiple gastric stromal tumors (Courtesy Dr. V. Penopoulos)

Total gastrectomy specimen. Brown arrows – Multiple gastric stromal tumors (Courtesy Dr. V. Penopoulos)

Total gastrectomy specimen. Brown arrows – Multiple gastric stromal tumors (Courtesy Dr. V. Penopoulos)

Total gastrectomy specimen. Brown arrows – Multiple gastric stromal tumors (Courtesy Dr. V. Penopoulos)
Esophageal Sphincter
(0 images)No images in this chapter yet.
Stomach
(0 images)No images in this chapter yet.
Duodenum
(0 images)No images in this chapter yet.